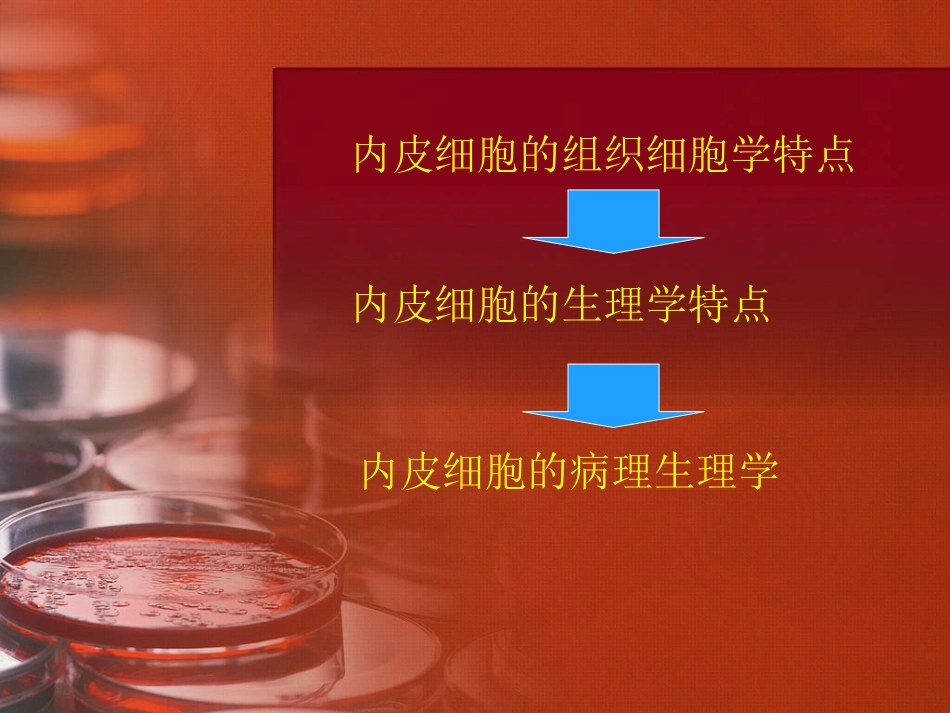

1、培基文库文档一经付费(服务费),不意味着购买了该文档的版权,仅供个人/单位学习、研究之用,不得用于商业用途,未经授权,严禁复制、发行、汇编、翻译或者网络传播等,侵权必究。
2、本站所有内容均由合作方或网友上传,本站不对文档的完整性、权威性及其观点立场正确性做任何保证或承诺!文档内容仅供研究参考,付费前请自行鉴别。如您付费,意味着您自己接受本站规则且自行承担风险,本站不退款、不进行额外附加服务。
3. 培基文库仅提供信息存储空间,仅对用户上传内容的表现方式做保护处理,对用户上传分享的文档内容本身不做任何修改或编辑,并不能对任何下载内容负责。
4. 本站不保证下载资源的准确性、安全性和完整性, 同时也不承担用户因使用这些下载资源对自己和他人造成任何形式的伤害或损失。
5、如文档侵犯商业秘密、侵犯著作权、侵犯人身权等,请点击文档标题下面“举报”,也可以联系客服投诉QQ:188878628。
Q、文档下载后会有水印吗?
A、文档预览未下载之前背景显示网站的名字“培基文库”,下载之后不带有任何关于培基文库名称、网址等网站本身信息水印。
Q、我下载的文件找不到了?
A、Windows电脑快捷键“Ctrl+j”,苹果(Mac)电脑按(“⌘+j”),(几乎适用所有的浏览器)